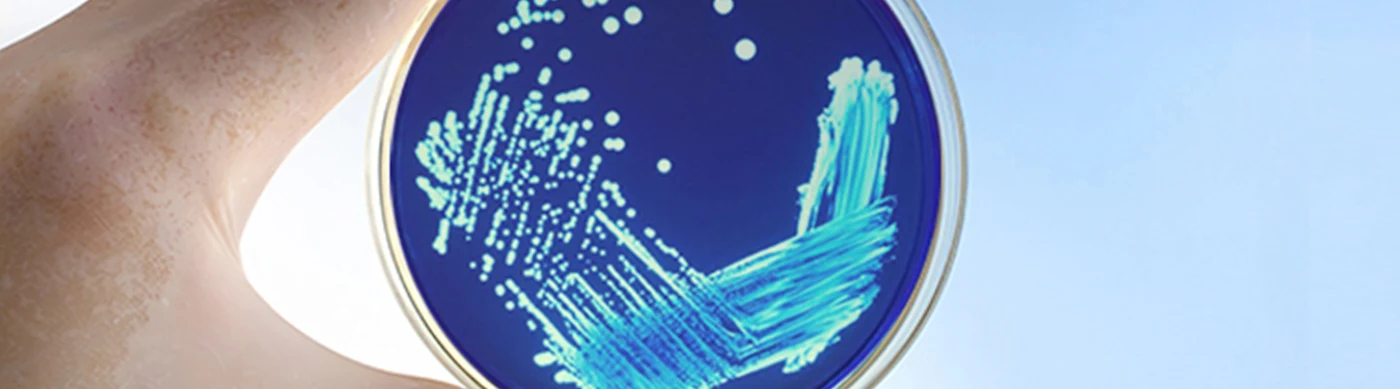
Hand holding a petri dish with blue agar and teal bacterial colonies growing.

An estimated 56,000-113,000 people are infected with the legionella bacteria in the United States, according to Legionella.org. Legionella can cause Legionnaires' disease, which is a severe form of lung inflammation usually caused by an infection. The Center for Disease Control (CDC) has noted that the number of cases of reported Legionnaires' disease increased 217% between 2000 and 2009. Older adults, smokers and other people with weakened immune systems are particularly susceptible to Legionnaires' disease.
Symptoms of Legionnaires' disease usually develop within two to 10 days of exposure to legionella bacteria and manifests in a headache, muscle pain, chills and a fever (usually 104 F or higher). Other signs and symptoms may include cough, shortness of breath, chest pain, nausea or vomiting, and in untreated or severe cases can cause death. Since the symptoms of Legionnaires' disease are similar to other illnesses, it can go undiagnosed and is likely underdiagnosed by doctors.
What is Legionella?
Legionella pneumophila (legionella) is a type of bacteria found naturally in freshwater environments such as lakes and streams. Documented man-made sources of legionella include cooling towers, swimming pools, domestic water systems and showers, ice-making machines, refrigerated cabinets, whirlpool spas, and fountains (to name a few). Most people become infected by legionella with inhalation of microscopic (aerosolized) water droplets containing the bacteria. Examples include spray from a shower, faucet, or whirlpool, or water in a ventilation system. Other transmission routes can include aspiration (liquids accidentally entering lungs via coughing or choking while drinking) and soils (a few cases have been linked to working in the garden or using contaminated potting soil). Legionella bacteria thrive in a narrow temperature range which includes the average temperature of the human body.
Legionella in the Healthcare Industry
Within the healthcare industry, specifically at properties operated as hospitals and nursing homes, legionella can be a sporadic but persistent problem since these operations usually require large and complex water systems. Combining the scope of the water system with germs that spread easily and occupants that are vulnerable to infection makes legionella one of the highest risk factors to owning and managing healthcare buildings.
The emerging concern for healthcare buildings includes cooling towers. Cooling towers use recirculated water systems to lower temperature and are typically part of a hospital building's heating, ventilation and air conditioning (HVAC) system. A cooling tower polluted with legionella will lead to a reduced cooling capacity which negatively influences system reliability and can lead to health risks.
In July 2016, the State of New York announced final regulations protecting against legionella in every cooling tower requiring all general hospitals and residential healthcare facilities in the state to adopt maintenance, sampling, and regular cleaning procedures. The regulations were the direct result of a 2015 outbreak of Legionnaires' disease from cooling tower mist that was polluted with legionella. 138 residents of the South Bronx were diagnosed with the disease and 16 people died from inhalation of the contaminated mist.
Legionella and Environmental Insurance Claims
Legionella can be alleged as a pollution condition as Legionnaires' disease only occurs where the level of bacteria within the water system is at a concentration high enough to cause Legionnaires' disease. Claims include bodily injury, property damage, remediation (clean-up costs) and legal expense and defense costs. Examples include the following:
Remediation Expense: $45,000
Small traces of legionella bacteria were found at a nursing home during a routine check of the water quality. The nursing home had to investigate and eliminate any risk posed by the low-levels of bacteria that were found to remove any consideration of the legionella found to cause Legionnaires' disease. Contractors treated the water system and a new cold water storage tank was temporarily installed at the home which served the residents until levels were found to be acceptable. Total costs to eliminate the bacteria were $45,000.Bodily Injury, Remediation, and Business Interruption: $700,000+ An elderly patient who suffered a type of lung disease received a bi-lateral lung transplant and was transferred to a monitoring and recovery facility. Shortly after being transferred, the patient had difficulty breathing and was diagnosed with Legionnaires' disease. Upon investigation, it was found that the patient was highly susceptible to contracting Legionnaires', and that the disease contributed to the ultimate mortality of the patient. The source of the legionella was found to be the recovery facility's water system. The recovery facility incurred medical costs from the bodily injury as well as the business interruption expenses from the time the facility was inoperable during investigation and remediation efforts. Total costs were shared by the recovery facility operator and building owner resulting in a payment of $700,000+ to settle the claim.
Legal Expense & Defense Costs: $100,000+
An insured operating a hospital was contacted by the local health department regarding notable reports of sickness like Legionnaires' disease within radius to buildings in the area with cooling towers. Within days of the contact, an employee at the hospital was diagnosed with Legionnaires' disease which led to testing of the building's HVAC system and cooling tower mist. While all tests were negative, a biofilm in the cooling tower was found that was positive for the legionella bacteria. The cooling tower was drained, cleaned, and retested for the bacteria. Ultimately, the insured's cooling tower was found to be installed after the first cases of the Legionnaires' were diagnosed, and so was determined not to be the source of the Legionnaires' cases in the area. While the insured was released from liability, legal expense and defense costs associated with the claim amounted to $100,000+ during investigations.
Building Related Illness and Insurance Exposures
Pollution insurance is a risk management tool utilized by property owners to mitigate their exposures to legionella. Claims and loss can arise from a variety of sources as noted above via the following liability routes (all with associated legal expense and defenses for investigation of allegations to prove negligence or fault on behalf of the accused party):
Remediation (Cleanup Costs): Legionella is naturally present in our buildings' water sources and often is not a part of a building's water quality testing parameters. Since the building's water systems are complex and can be large, a remediation effort of the entire system can be costly and require multiple efforts.
Bodily Injury: Legionella, if contracted by a person, and remains undiagnosed in a hospital or nursing home, can cause death. Given the depressed immune systems of occupants in those buildings, symptoms and incubation time can be accelerated and exacerbated.
Property Damage: Given legionella is within the building water systems and constructs of the property, accessing the source of the legionella within the water system may result in property damage. Such property damage may be exacerbated by the need for multiple floor or wing access at a large square foot property with upgraded sensors and technology embedded into the design (i.e. a LEED design building).
In each of the above exposures, pollution insurance in conjunction with other risk management protocols and procedures for inhibiting legionella concerns can assist owners and operators of healthcare properties in managing their liabilities associated with legionella.
Additional Prevention Measures for Legionella Exposure
Development of a Water Management Program with continual oversight is the key to managing legionella exposures. The following prevention measures are often helpful as a part of this program:
Documentation of the current building water system and components using text and flow diagrams regarding the water source, distribution, and heating.
Implementation of control system which can include automatic testing and monitoring programs, chlorine treatments, or controlling temperature to inhibit legionella multiplication and growth.
Communication of program maintenance including inspections and corrective measures involving building owners, managers, administrators, facility maintenance and engineering employees, local and state health officials.
Resources and Additional Information
For additional resources and information, please visit the following websites:
Legionella.org: http://legionella.org/faqs/general-public/
Center for Disease Control (CDC): https://www.cdc.gov/legionella/index.html
Mayo Clinic: https://www.mayoclinic.org/diseases-conditions/legionnaires-disease/symptoms-causes/syc-20351747
NY Department of Buildings: https://www1.nyc.gov/site/buildings/safety/cooling-tower-registration.page
HETI risk management firm: www.hetiservices.com
This post is a part of the Tokio Marine Specialty Environmental team's efforts to educate on protections and liabilities for environmental risks. The information contained herein is for discussions and informational purposes and is not intended to be a full disclosure or complete analysis of the liabilities or risks posed to insured(s) in the marketplace.